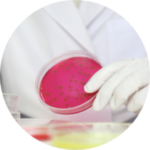
Products For MICROBIOLOGY

PoreTek™ is an Indian leading manufacturing and supplier corporation for innovative and top-quality high-tech products range used for purification and separation pharmaceutical, biopharmaceutical, biotechnology, food industries, analytical & microbiology labs, life science and research care. Core competency of PoreTek™ is in membrane based products & devices and filtration hardware along with other laboratory consumables. Our turn- key capabilities and facilities have assisted our esteem customers quickly and effectively by providing a best in class quality products and laboratory solutions. Our main aim continuously focused on effectively introduces new, innovative and better products into their markets for intended applications. PoreTek™ founded in 2018 with a strong commitment to science to deliver best in class products with cutting edge solutions and our expertise lies into develop and supply membrane filtration technology among various industries as well research Institutes to cater pre-filtration to final/sterile filtration application.
Welcome to PoreTekTM
We' ve built a long standing relationship based on trust
Regulatory Compliance
All filtration products are manufactured in clean environment and validated as per ‘’Parenteral Drug Association Technical Report 26” and comply with: USP VI for Toxicity, USP 661 for extractable, USFDA 21CFR part 210, 3b (6) for non-fiber release filter, USP 788 & 789 for particulate matter in injectable and ophthalmic solution, USP 643 for TOC, 21 CFR 177 for indirect food additives and PDA TR 26 for filter qualification and validation.
The Company offers products & services mainly into six business segments:
The Backbone of our Company
- Filtration Solutions for Laboratory & R&D
- Products for microbiological application
- Environmental Product portfolio
- Process and Production Filtration
- Diagnostic and Biotechnology
- Filtration Hardware Services
“Be ready to produce quality products with us”
To Receive Top Quality Products
Copyright ©2026 PoreTek | All Rights Reserved |
Designed by Wraith Technologies